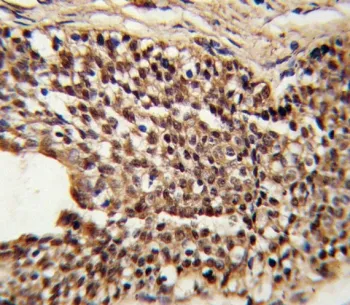
Triosephosphate isomerase Antibody - image 1

Triosephosphate isomerase Antibody
CAT:
800-F54404-0.08ML
Size:
0.08 mL
This product is intended to Research Use Only. Not for Diagnostic or In Vivo Applications.
Price:
Ask
- Availability: 24/48H Stock Items & 2 to 6 Weeks non Stock Items.
- Dry Ice Shipment: No